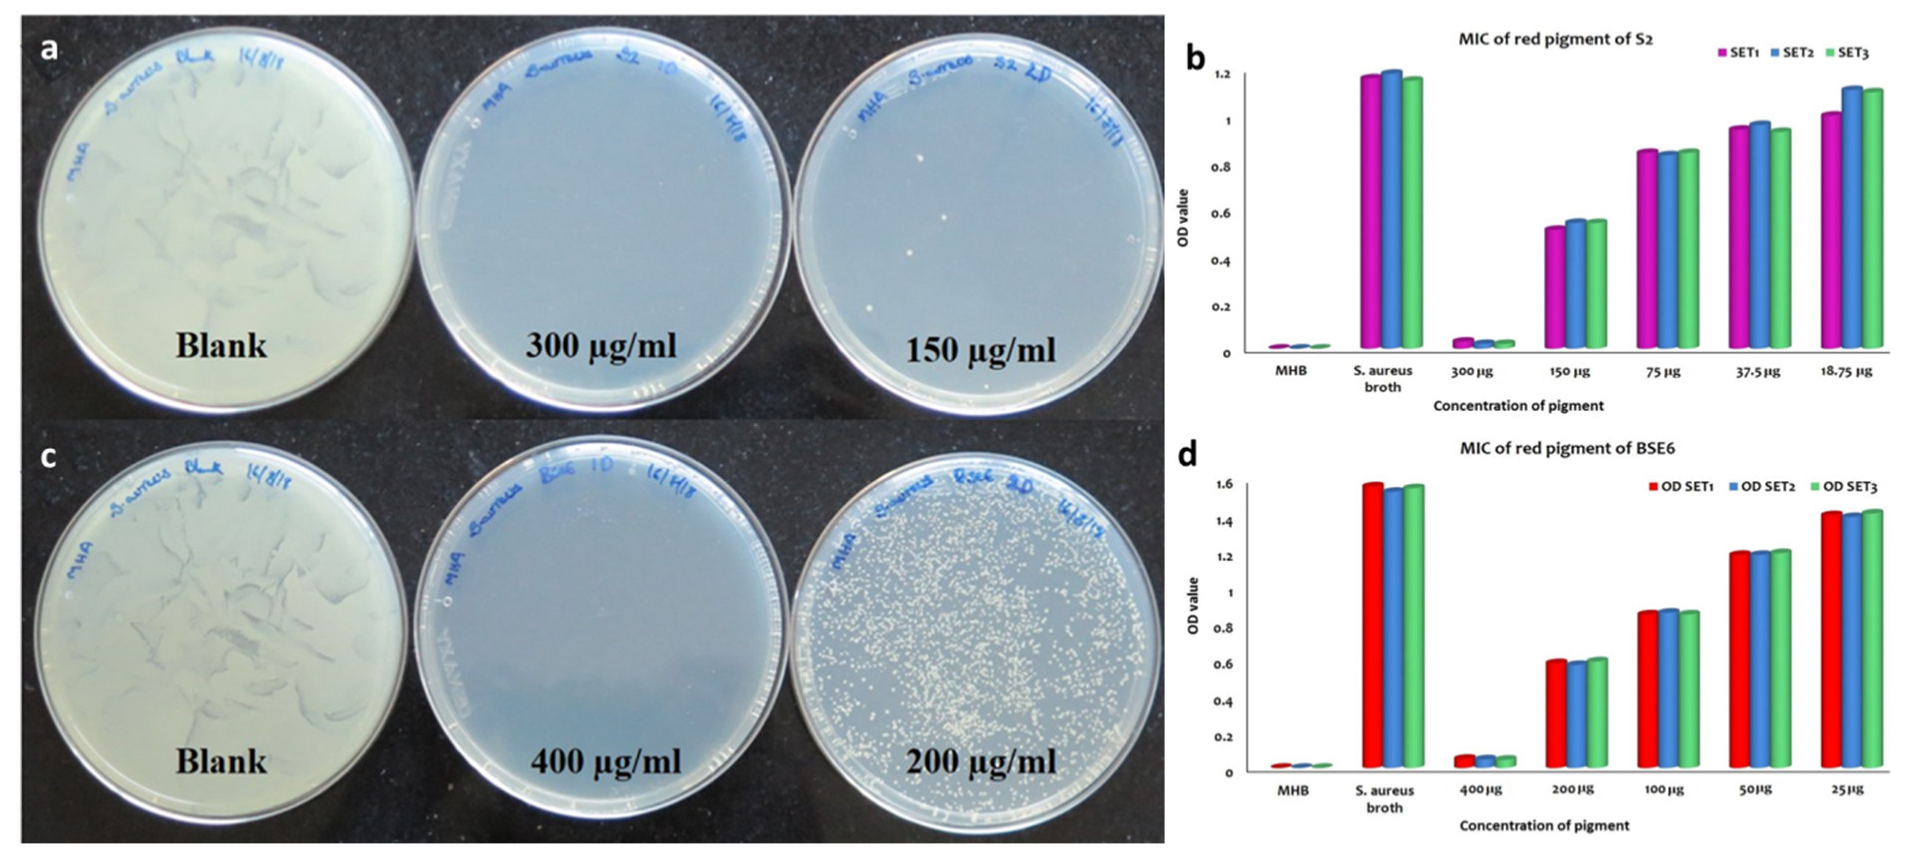
Microorganisms 08 00556 g008 Microorganisms 08 00556 g008

Applications of Prodigiosin Extracted from Marine Red Pigmented Bacteria Zooshikella sp. and Actinomycete Streptomyces sp.
Abstract
1. Introduction
2. Material and Methods
2.1. Study Area
2.2. Collection of Samples
2.3. Cultivation and Isolation of Pigmented Bacteria
2.4. Storage
2.5. Molecular Characterization of Pigmented Bacteria
2.5.1. Genomic DNA Extraction
2.5.2. PCR Amplification of 16S rRNA Analysis
2.5.3. RAPD-PCR Analysis
2.5.4. RFLP Analysis of Amplified 16S rRNA
2.5.5. Sequencing and Phylogenetic Analysis
2.5.6. Nucleotide Sequence Accession Numbers
2.6. Extraction and Preparation of Crude Pigmented Compounds
2.7. Antibacterial Properties of Pigment Extracts
2.7.1. Human Bacterial Pathogens
2.7.2. Preparation of Human Pathogenic Bacterial Inoculums
2.7.3. Antibacterial Assays
2.7.4. Minimum Inhibitory Concentration (MIC) and Minimum Bactericidal Concentration (MBC) Assays
2.8. Food Colorant and Staining Applications of Pigments
2.9. Statistical Analysis
3. Characterization of the Pigment
3.1. Thin Layer Chromatography Analysis (TLC)
3.2. High Performance Liquid Chromatography Analysis (HPLC)
3.3. UV-Visible Spectrophotometry
3.4. Fourier-Transform Infrared Spectroscopy (FT-IR)
3.5. Gas Chromatography and Mass Spectrometry (GC-MS) Analysis
3.6. Proton NMR Spectroscopy Analysis
4. Results and Discussion
4.1. Isolation of Marine Pigmented Bacteria
4.2. Antibacterial Activity of the Pigment
4.3. Application of Pigments as Strainers and Food Colorants
4.4. Purification and Identification of the Pigment
4.5. Identification of the Potent Strains S2.1 and BSE6.1
5. Conclusions
Supplementary Materials
Author Contributions
Funding
Acknowledgments
Conflicts of Interest
References
- Aylward:, F.O.; Eppley, J.M.; Smith, J.M.; Chavez, F.P.; Scholin, C.A.; DeLong, E.F. Microbial community transcriptional networks are conserved in three domains at ocean basin scales. PNAS 2015, 112, 443–448. [Google Scholar] [CrossRef]
- Grossart, H.; Thorwest, M.; Plitzko, I.; Brinkhoff, T.; Simon, M.; Zeeck, A. Production of a blue pigment (Glaukothalin) by marine Rheinheimera spp. Int. J. Microbiol. 2009, 2009, 701735. [Google Scholar] [CrossRef]
- Soliev, A.B.; Hosokawa, K.; Enomoto, K. Bioactive pigments from marine bacteria: Applications and physiological roles. Evid. Based. Complement. Alternat. Med. 2011, 2011, 670349. [Google Scholar] [CrossRef]
- Ramesh, C.H.; Vinithkumar, N.V.; Kirubagaran, R.; Venil, C.K.; Dufosse, L. Multifaceted applications of microbial pigments: Current knowledge, challenges, and future directions for public health implications. Microorganisms 2019, 7, 186. [Google Scholar] [CrossRef]
- Ramesh, C.H.; Vinithkumar, N.V.; Kirubagaran, R. Marine pigmented bacteria: A prospective source of antibacterial compounds. J. Nat. Sci. Biol. Med. 2019, 10, 104–113. [Google Scholar] [CrossRef]
- Chin, Y.W.; Balunas, M.J.; Chai, H.B.; Kinghorn, A.D. Drug discovery from natural sources. AAPS J. 2006, 8, E239–E253. [Google Scholar] [CrossRef] [PubMed]
- Venil, C.K.; Zakaria, Z.A.; Ahmad, W.A. Bacterial pigments and their applications. Process. Biochem. 2013, 48, 1065–1079. [Google Scholar] [CrossRef]
- Numan, M.; Bashir, S.; Mumtaz, R.; Tayyab, S.; Rehman, N.U.; Khan, A.L.; Shinwari, Z.K.; Al-Harrasi, A. Therapeutic applications of bacterial pigments: A review of current status and future opportunities. 3 Biotech 2018, 8, 207. [Google Scholar] [CrossRef] [PubMed]
- Ramesh, C.; Mohanraju, R.; Murthy, K.N.; Karthick, P. Molecular characterization of marine pigmented bacteria showing antibacterial activity. Indian J. Mar. Sci. 2017, 46, 2081–2087. [Google Scholar]
- Brown, A.E.; Smith, R.H. Benson: Microbiological Applications Lab Manual, 14th ed.; The McGraw−Hill Companies: New York, NY, USA, 2016. [Google Scholar]
- Stafsnes, M.H.; Bruheim, P. Pigmented Marine Heterotrophic Bacteria. In Marine Biomaterials; Kim, S.K., Ed.; CRC Press: Boca Raton, FL, USA, 2013; pp. 117–148. [Google Scholar]
- Ramesh, C.; Anwesh, M.; Vinithkumar, N.V.; Kirubagaran, R. Draft genome sequence of marine sediment-derived red pigmented bacteria Zooshikella sp. strain S2.1 with potential biomedical applications. Genomics 2019, 112, 805–808. [Google Scholar] [CrossRef]
- Lane, D.J. 16S/23S rRNA sequencing. In Nucleic Acid Techniques in Bacterial Systematics; Stackebrandt, E., Goodfellow, M., Eds.; John Wiley & Sons Inc.: New York, NY, USA, 1991; pp. 115–175. [Google Scholar]
- Tamura, K.; Stecher, G.; Peterson, D.; Filipski, A.; Kumar, S. MEGA6: Molecular evolutionary genetic analysis version 6.0. Mol. Biol. Evol. 2013, 30, 2725–2729. [Google Scholar] [CrossRef] [PubMed]
- Gontcharova, V.; Youn, E.; Wolcott, R.D.; Hollister, E.B.; Gentry, T.J.; Dowd, S.E. Black box chimera check (B2C2): A windows-based software for batch depletion of chimeras from bacterial 16S rRNA gene datasets. Open Microbiol. J. 2010, 4, 47–52. [Google Scholar] [CrossRef] [PubMed]
- Thompson, J.D. CLUSTAL W: Improving the sensitivity of progressive multiple sequence alignment through sequence weighting, position-specific gap penalties and weight matrix choice. Nucleic Acids Res. 1994, 22, 4673–4680. [Google Scholar] [CrossRef] [PubMed]
- Tamura, K.; Nei, M.; Kumar, S. Prospects for inferring very large phylogenies by using the neighbor-joining method. Proc. Natl. Acad. Sci. USA 2004, 101, 11030–11035. [Google Scholar] [CrossRef]
- Felsenstein, J. Confidence limits on phylogenies: An approach using the bootstrap. Evolution 1985, 39, 783–791. [Google Scholar] [CrossRef]
- Wietz, M.; Mansson, M.; Gotfredsen, C.H.; Larsen, T.O.; Gram, L. Antibacterial compounds from marine Vibrionaceae isolated on a global expedition. Mar. Drugs 2010, 8, 2946–2960. [Google Scholar] [CrossRef]
- Bauer, A.W.; Kirby, W.M.M.; Sherris, J.S.; Turk, M. Antibiotic susceptibility by standardized single disc method. Am. J. Clin. Pathol. 1966, 45, 493–496. [Google Scholar] [CrossRef]
- CLSI. Methods for Dilution Antimicrobial Susceptibility Tests for Bacteria that Grow Aerobically; CLSI: Wayne, PA, USA, 2006; Volume CLSI documents M27-S3; p. 940. [Google Scholar]
- Wiegand, I.; Hilpert, K.; Hancock, R.E.W. Agar and broth dilution methods to determine the minimal inhibitory concentration (MIC) of antimicrobial substances. Nat. Protocol. 2008, 3, 163–175. [Google Scholar] [CrossRef]
- Pouchert, C.J. The Aldrich Library of FT-IR Spectra, 1st ed.; Aldrich: Milwaukee, WI, USA, 1985. [Google Scholar]
- Lee, J.S.; Kim, Y.S.; Park, S.; Kim, J.; Kang, S.J.; Lee, M.H.; Ryu, S.; Choi, J.M.; Oh, T.K.; Yoon, J.H. Exceptional production of both prodigiosin and cycloprodigiosin as major metabolic constituents by a novel marine bacterium, Zooshikella rubidus S1-1. Appl. Environ. Microbiol. 2011, 77, 4967–4973. [Google Scholar] [CrossRef]
- Siva, R.; Subha, K.; Bhakta, D.; Ghosh, A.R.; Babu, S. Characterization and enhanced production of prodigiosin from the spoiled coconut. Appl. Biochem. Biotechnol. 2012, 166, 187–196. [Google Scholar] [CrossRef]
- Oh, E.J.; Kwon, J.H.; Kim, S.Y.; In, S.J.; Lee, D.G.; Cha, M.Y.; Kang, H.C.; Hwang-Bo, J.; Lee, Y.H.; Chung, I.S.; et al. Red pigment produced by Zooshikella ganghwensis inhibited the growth of human cancer cell lines and MMP-1 gene expression. Appl. Biol. Chem. 2016, 59, 567–571. [Google Scholar] [CrossRef]
- Song, M.J.; Bae, J.; Lee, D.S.; Kim, C.H.; Kim, J.S.; Kim, S.W.; Hong, S.I. Purification and characterization of prodigiosin produced by integrated bioreactor from Serratia sp. KH95. J. Biosci. Bioeng. 2006, 101, 157–161. [Google Scholar] [CrossRef] [PubMed]
- Fehér, D.; Barlow, R.S.; Lorenzo, P.S.; Hemscheidt, T.K. A 2-Substituted Prodiginine, 2-(p-Hydroxybenzyl) prodigiosin, from Pseudoalteromonas rubra. J. Nat. Prod. 2008, 71, 1970–1972. [Google Scholar] [CrossRef] [PubMed]
- Wang, Y.; Nakajima, A.; Hosokawa, K.; Soliev, A.B.; Osaka, I.; Arakawa, R.; Enomoto, K. Cytotoxic prodigiosin family pigments from Pseudoalteromonas sp. 1020R isolated from the pacific coast of Japan. Biosci. Biotechnol. Biochem. 2012, 76, 1229–1232. [Google Scholar] [CrossRef] [PubMed]
- Yi, H.; Chang, Y.; Oh, H.W.; Bae, K.S.; Chun, J. Zooshikella ganghwensis gen. nov., sp. nov., isolated from tidal flat sediments. Int. J. Syst. Evol. Microbiol. 2003, 53, 1013–1018. [Google Scholar] [CrossRef]
- Ramaprasad, E.V.V.; Bharti, D.; Sasikala, C.; Ramana, C.V. Zooshikella marina sp. nov. a cycloprodigiosin-and prodigiosin-producing marine bacterium isolated from beach sand. Int. J. Syst. Evol. Microbiol. 2015, 65, 4669–4673. [Google Scholar] [CrossRef]
- Jafarzade, M.; Yahya, N.A.; Mohamad, S.; Usup, G.; Ahmad, A. Isolation and characterization of pigmented bacteria showing antimicrobial activity from Malaysian marine environment. Mal. J. Microbiol. 2013, 9, 152–160. [Google Scholar] [CrossRef]
- Rehman, Z.; Alam, I.; Kamau, A.A.; Bajic, V.B. Genome sequence analysis of Zooshikella ganghwensis strain VG4 and its potential for the synthesis of antimicrobial metabolites. Biotechnol. Rep. 2018, 19, e00278. [Google Scholar] [CrossRef]
- Kim, Y.; Choi, J. Dyeing properties of microbial prodiginine from Zooshikella rubidus for silk fabrics. Fibers Polym. 2015, 16, 1981–1987. [Google Scholar] [CrossRef]
- Ritchie, K.B.; Schwarz, M.; Mueller, J.; Lapacek, V.A.; Merselis, D.; Walsh, C.J.; Luer, C.A. Survey of antibiotic-producing bacteria associated with the epidermal mucus layers of rays and skates. Front. Microbiol. 2017, 8, 1050. [Google Scholar] [CrossRef]
- Hakvåg, S.; Fjærvik, E.; Klinkenberg, G.; Borgos, S.E.F.; Josefsen, K.D.; Ellingsen, T.E.; Zotchev, S.B. Violacein-producing Collimonas sp. from the sea surface microlayer of costal waters in Trøndelag, Norway. Mar. Drugs 2009, 7, 576–588. [Google Scholar] [CrossRef] [PubMed]
- Brinkhoff, T.; Bach, G.; Heidorn, T.; Liang, L.; Schlingloff, A.; Simon, M. Antibiotic production by a Roseobacter clade-affiliated species from the German Wadden Sea and its antagonistic effects on indigenous isolates. Appl. Environ. Microbiol. 2004, 70, 2560–2565. [Google Scholar] [CrossRef] [PubMed]

| S.No | Pigmented Bacterial Strain | Isolation Source | GenBank Accession Number | Sequence Similarity % | Identified as |
|---|---|---|---|---|---|
| 1. | SW1 | Seawater | MK680109 | 99.62 | Pseudoalteromonas peptidolytica |
| 2. | SW2 | Seawater | MK680110 | 99.02 | Pseudoalteromonas peptidolytica |
| 3. | SW4 | Seawater | MK680111 | 99.27 | Gordonia terrae |
| 4. | CO2 | Conus miles | ND | ND | |
| 5. | SQ2.3 | Juvenile squid | ND | ND | |
| 6. | PC3 | MK680107 | 96.66 | Nitratireductor basaltis | |
| 7. | NBE2 | Unidentified nudibranch egg mass | MK680106 | 98.71 | Salinicoccus roseus |
| 8. | MSW2 | Seawater | MK680105 | 99.42 | Idiomarina sediminum |
| 9. | CSW3 | Seawater | MK680104 | 99.34 | Idiomarina sediminum |
| 10. | BSP1 | Unidentified violet Sponge | MK680103 | 99.41 | Pseudomonas aeruginosa |
| 11. | CO8 | Conus miles | ND | ND | |
| 12. | DA1 | Seawater | ND | ND | |
| 13. | BSE6.1 | Sediment | MK951781 | 99.71 | Streptomyces sp. |
| 14. | S2.1 | Sediment | MK680108 | 99.77 | Zooshikella marina |
| 15. | BSC | Holothuria artra | MK680112 | 96.64 | Serratia marcescens |
| 16. | AB4 | Acetabularia acetabulum | MK680101 | 95.65 | Photobacterium ganghwense |
| 17. | AB5 | Acetabularia acetabulum | MK680102 | 97.87 | Photobacterium ganghwense |
© 2020 by the authors. Licensee MDPI, Basel, Switzerland. This article is an open access article distributed under the terms and conditions of the Creative Commons Attribution (CC BY) license (http://creativecommons.org/licenses/by/4.0/).
Share and Cite
Ramesh, C.; Vinithkumar, N.V.; Kirubagaran, R.; Venil, C.K.; Dufossé, L. Applications of Prodigiosin Extracted from Marine Red Pigmented Bacteria Zooshikella sp. and Actinomycete Streptomyces sp. Microorganisms 2020, 8, 556. https://doi.org/10.3390/microorganisms8040556
Ramesh C, Vinithkumar NV, Kirubagaran R, Venil CK, Dufossé L. Applications of Prodigiosin Extracted from Marine Red Pigmented Bacteria Zooshikella sp. and Actinomycete Streptomyces sp. Microorganisms. 2020; 8(4):556. https://doi.org/10.3390/microorganisms8040556
Chicago/Turabian StyleRamesh, Chatragadda, Nambali Valsalan Vinithkumar, Ramalingam Kirubagaran, Chidambaram Kulandaisamy Venil, and Laurent Dufossé. 2020. "Applications of Prodigiosin Extracted from Marine Red Pigmented Bacteria Zooshikella sp. and Actinomycete Streptomyces sp." Microorganisms 8, no. 4: 556. https://doi.org/10.3390/microorganisms8040556
APA StyleRamesh, C., Vinithkumar, N. V., Kirubagaran, R., Venil, C. K., & Dufossé, L. (2020). Applications of Prodigiosin Extracted from Marine Red Pigmented Bacteria Zooshikella sp. and Actinomycete Streptomyces sp. Microorganisms, 8(4), 556. https://doi.org/10.3390/microorganisms8040556

